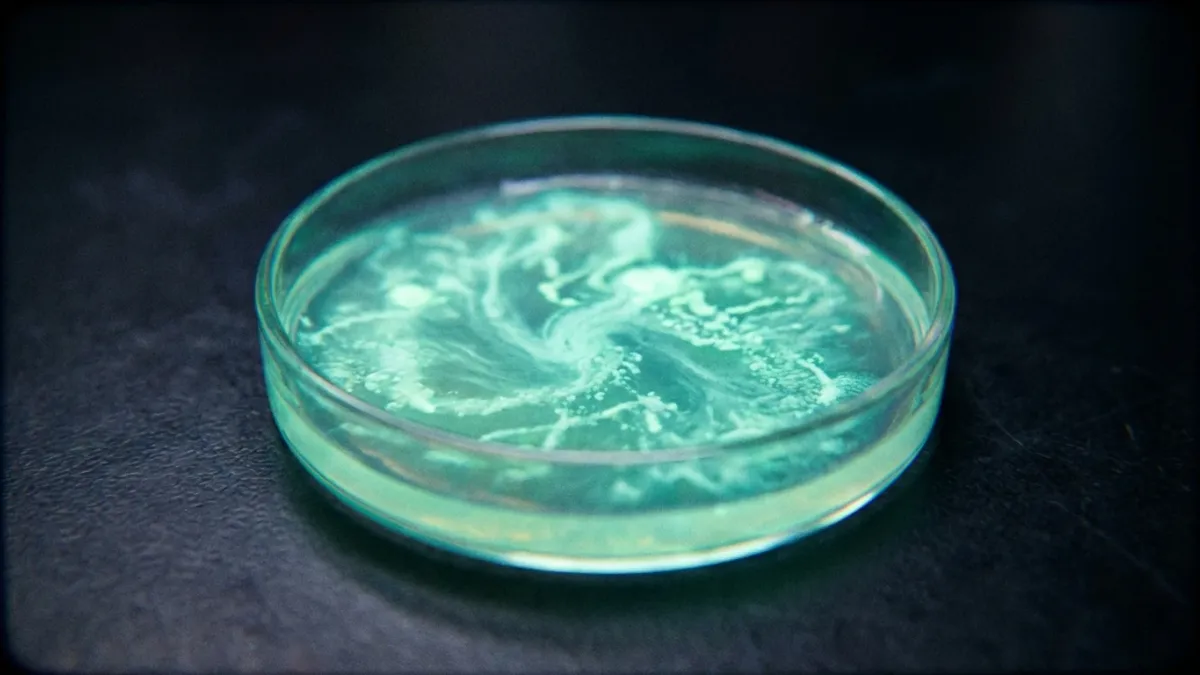

Formaldehyde: Unlocking a Sustainable Future with an Ancient Molecule
Formaldehyde, one of the universe's most abundant molecules, is being re-evaluated not just for its widespread industrial uses but also for its critical role in a sustainable, defossilized society. Researchers are exploring its potential in renewable energy, carbon capture, and biomass valorization, recognizing its versatile C1 chemistry as a pathway to address global sustainability challenges.
By Rodil, Deska, Prechtl